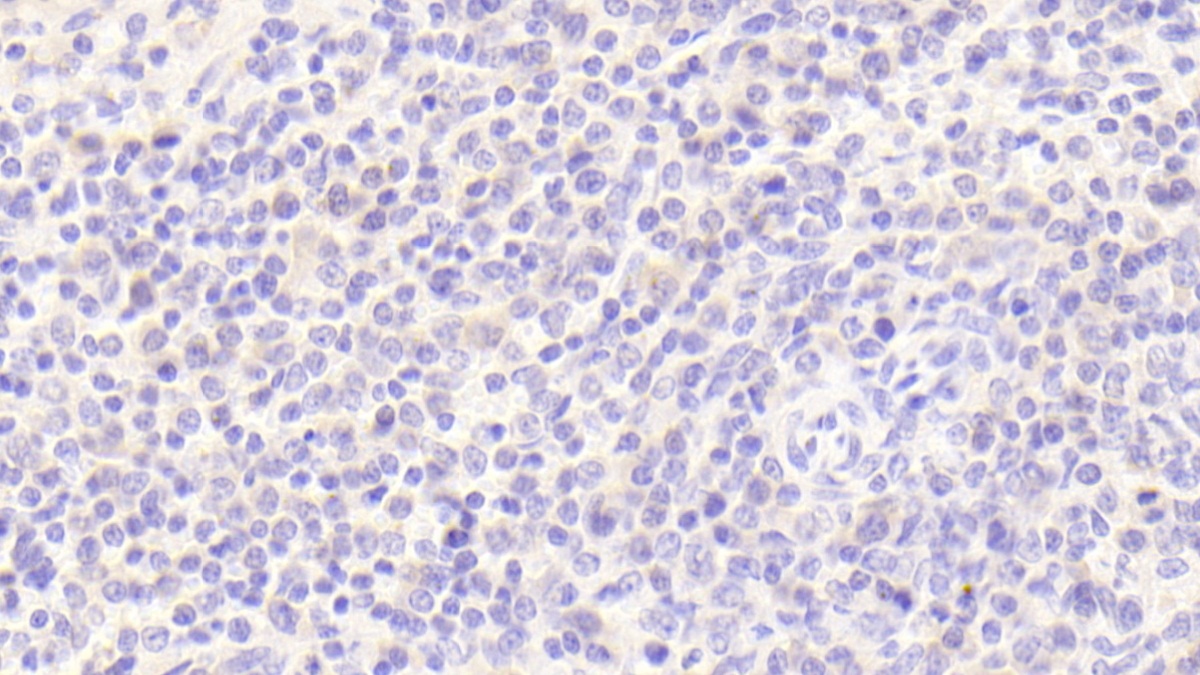

Polyclonal Antibody to Calcium Modulating Ligand (CAMLG)


Product No.: PAC356Hu01
Organism species: Homo sapiens (Human)

Polyclonal Antibody to Calcium And Integrin Binding Protein 1 (CIB1)


Product No.: PAC381Hu01
Organism species: Homo sapiens (Human)

Polyclonal Antibody to Immunoglobulin A1 (IgA1)


Product No.: PAE778Hu05
Organism species: Homo sapiens (Human)

Polyclonal Antibody to Tissue Specific Transplantation Antigen P35B (TSTA3)


Product No.: PAC818Hu01
Organism species: Homo sapiens (Human)

Polyclonal Antibody to Interleukin 4 (IL4)


Product No.: PAA077Hu06
Organism species: Homo sapiens (Human)
Polyclonal Antibody to Complement Factor P (CFP)


Product No.: PAA783Hu02
Organism species: Homo sapiens (Human)

Polyclonal Antibody to Cytokine Inducible SH2 Containing Protein (CISH)


Product No.: PAC383Hu01
Organism species: Homo sapiens (Human)

Polyclonal Antibody to Dishevelled Associated Activator Of Morphogenesis 1 (DAAM1)


Product No.: PAC427Hu01
Organism species: Homo sapiens (Human)

Polyclonal Antibody to Dyskerin (DKC)


Product No.: PAC446Hu01
Organism species: Homo sapiens (Human)

Polyclonal Antibody to FK506 Binding Protein 2 (FKBP2)


Product No.: PAC479Hu01
Organism species: Homo sapiens (Human)
Polyclonal Antibody to Homing Associated Cell Adhesion Molecule (HCAM)


Product No.: PAA670Hu08
Organism species: Homo sapiens (Human)

Polyclonal Antibody to Secernin 1 (SCRN1)


Product No.: PAC836Hu01
Organism species: Homo sapiens (Human)

Polyclonal Antibody to Antigen Peptide Transporter 2 (TAP2)


Product No.: PAD112Hu01
Organism species: Homo sapiens (Human)
Polyclonal Antibody to Complement Component 9 (C9)


Product No.: PAB823Hu08
Organism species: Homo sapiens (Human)

Polyclonal Antibody to Growth Arrest Specific Protein 6 (GAS6)

